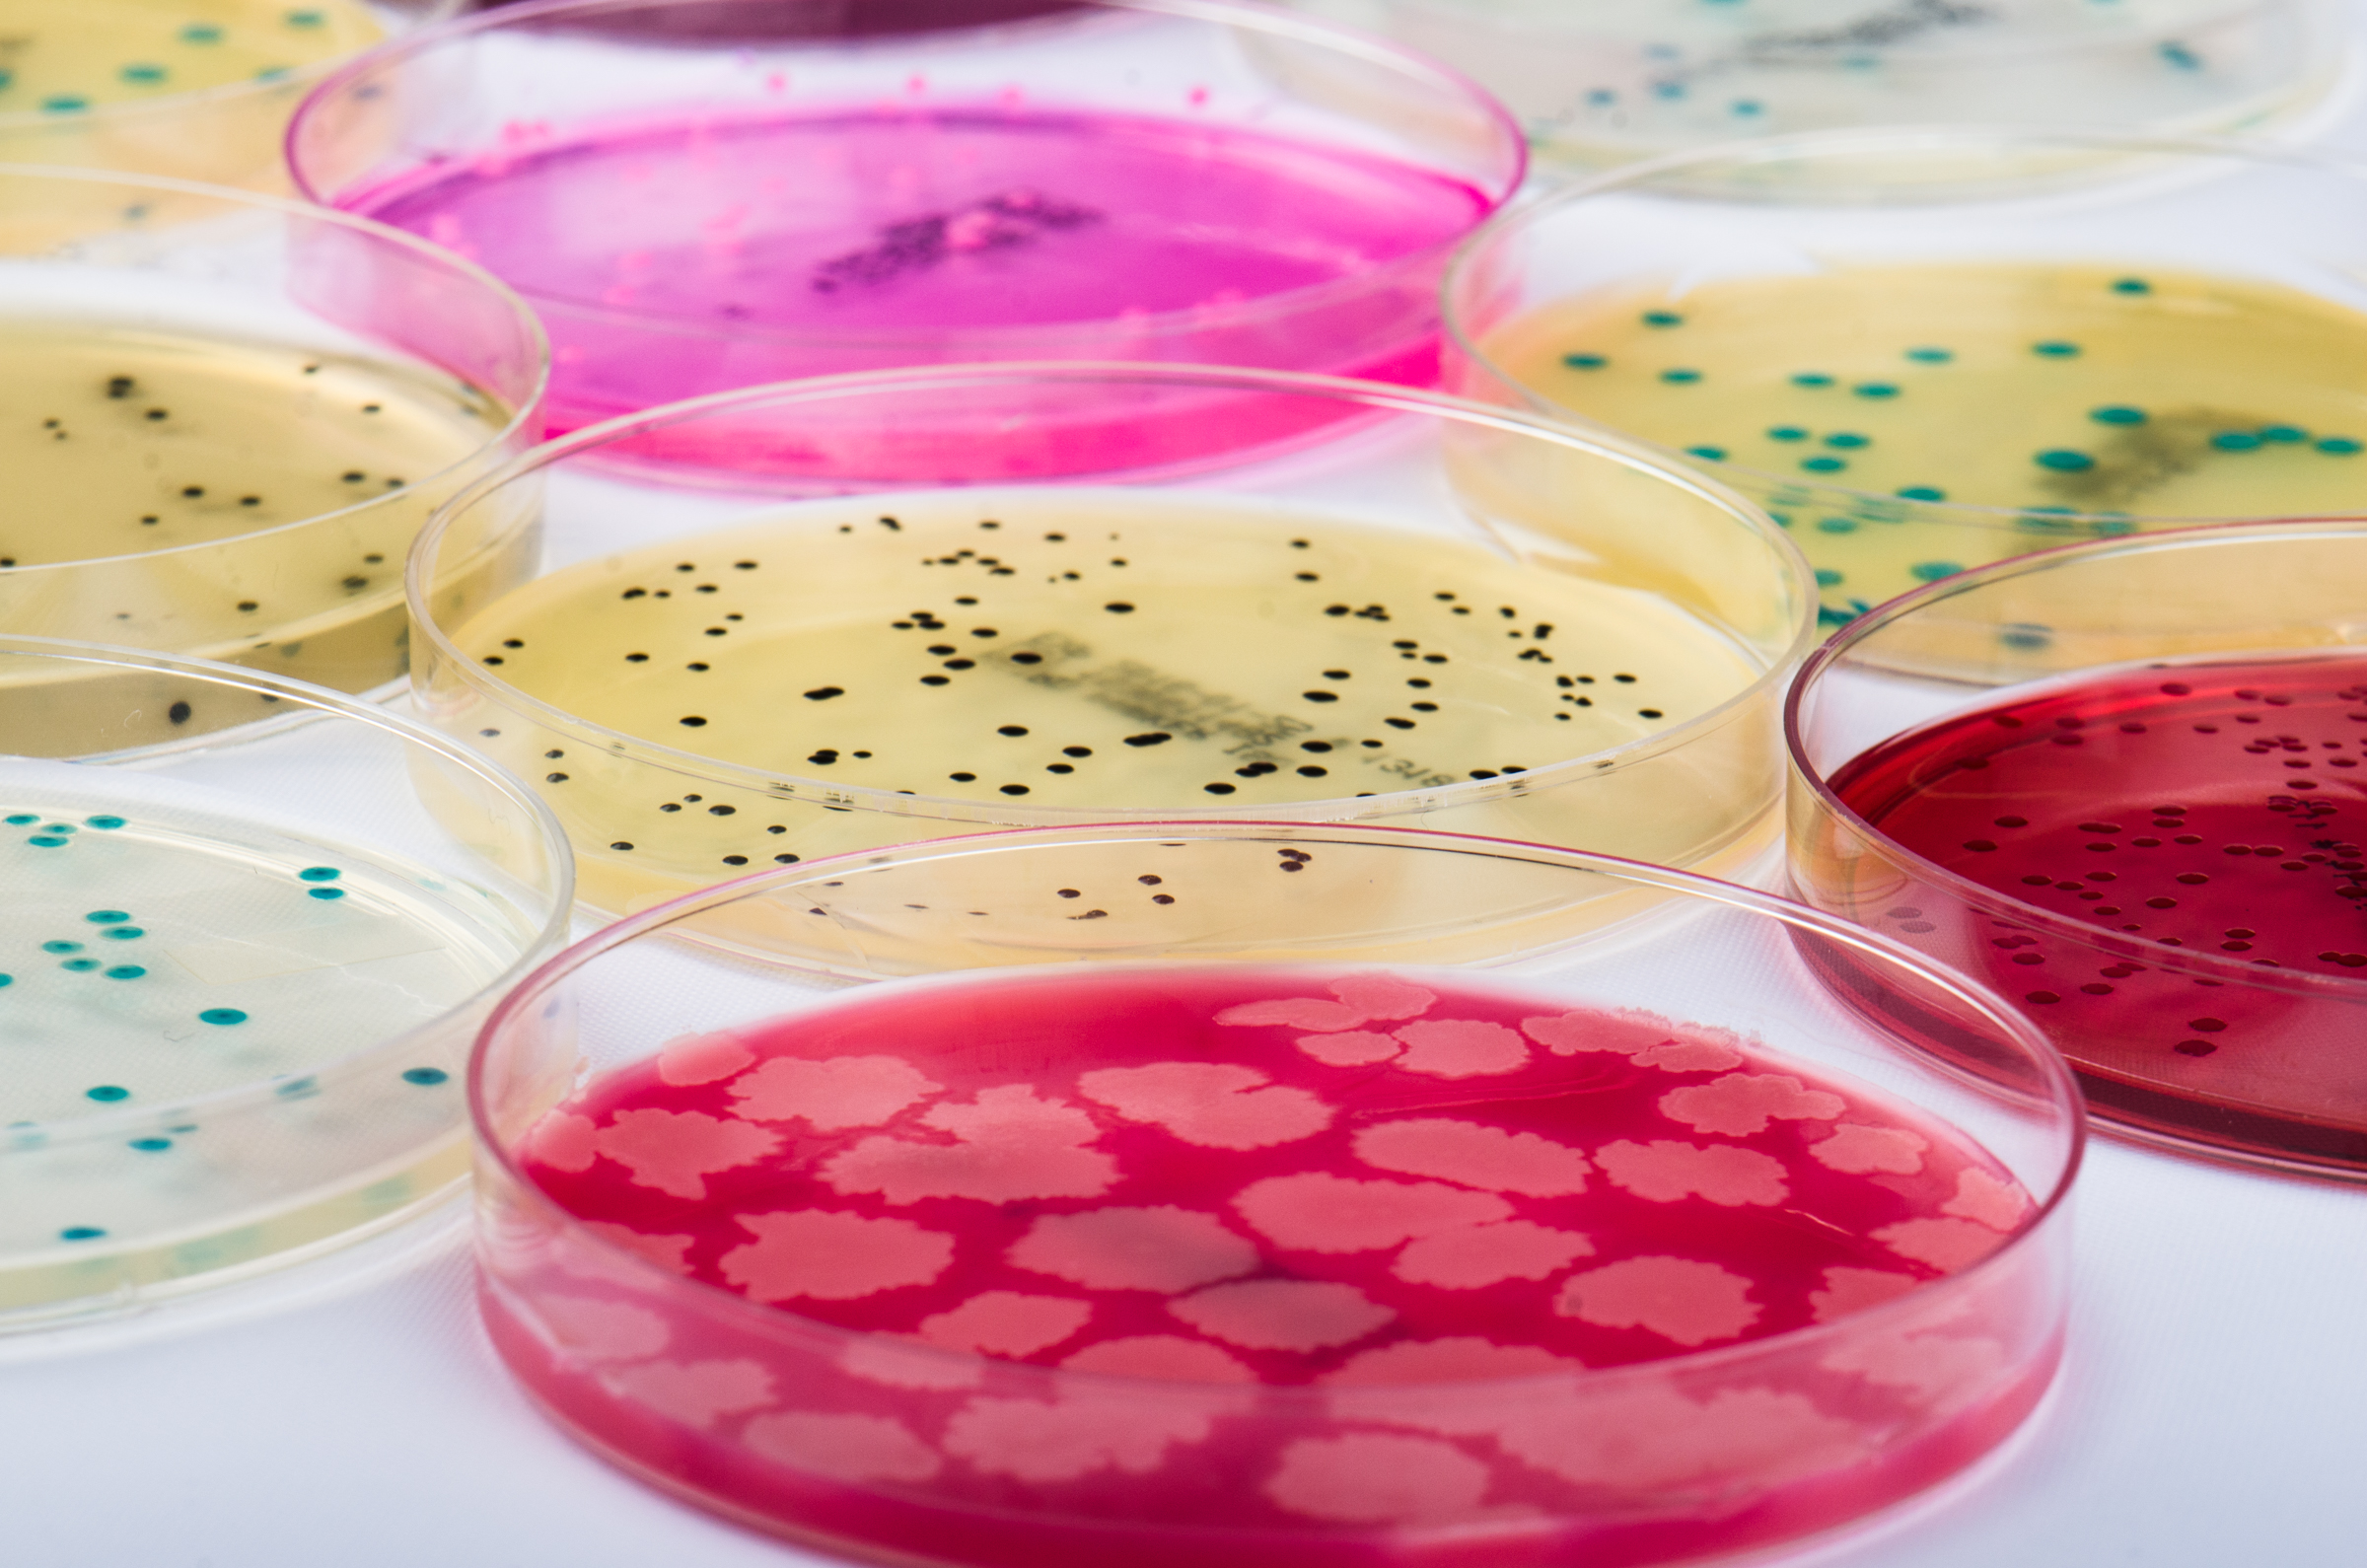
Procescontrole van microbiologische analyses is essentieel voor kwaliteitsborging

Veel voedingsmiddelenproducenten bemonsteren hun producten en laten daarvan in een laboratorium – hun eigen of extern – microbiologische analyses uitvoeren. Om aan de opgestelde HACCP-eisen of andere voorschriften te voldoen, wordt volgens bepaalde schema’s bemonsterd en worden volgens vaste procedures de microbiologische bepalingen gedaan. Aan de hand van de uitkomsten worden belangrijke conclusies getrokken: kan deze batch of kunnen deze producten veilig de productielocatie verlaten? Of moet de productie acuut worden stopgezet, de producten worden afgewaardeerd (gedowngrade) of moet er zelfs een recall plaatsvinden?
Hoe betrouwbaar zijn de uitkomsten?
Het stopzetten van de productie of in het uiterste geval zelfs het in gang zetten van een recall heeft een grote impact. Genoeg reden om zeker te willen weten dat de uitkomsten van het microbiologisch onderzoek betrouwbaar zijn. Toch zijn er laboratoria waar de analyses niet of nauwelijks gecontroleerd worden. Gesteld kan worden dat de veiligheidsrisico’s in de productie dan onvoldoende geborgd zijn.
Werken met referentiemateriaal biedt zekerheid
Toch zijn er ook steeds meer laboratoria die procescontroles invoeren en daarvoor gebruik maken van microbiologische referentiematerialen. Wanneer dagelijks referentiemateriaal het hele analyseproces doorloopt biedt dat zekerheid wat betreft de gebruikte methode, maar ook of de gebruikte materialen als media, filters en pipetten van de juiste kwaliteit zijn. Daarnaast laat het zien of analisten de juiste procedure volgen en of de apparatuur goed gewerkt heeft. Zijn de supplementen wel aan het voedingsmedium toegevoegd bijvoorbeeld? Een eenvoudig voorbeeld: wanneer men een referentiemateriaal Salmonella het analyseproces laat doorlopen en na telling voldoet de uitkomst aan de opgegeven waarden, is duidelijk dat alle randvoorwaarden van het proces in orde zijn.
Vals positieve of negatieve uitslagen kunnen snel onderschept worden
Ook biedt procescontrole garanties met betrekking tot vals positieve of vals negatieve uitkomsten van productmonsters. Het kan bijvoorbeeld voorkomen dat in een laboratorium een voedingsbodem van dusdanig slechte kwaliteit is, dat er veel te weinig bacteriële groei mogelijk is. De vals negatieve uitslagen die hieruit voortkomen kunnen door het uitvoeren van procescontrole snel herleid worden. Omdat er dan ook nauwelijks groei te zien is van het referentiemateriaal, kan de fout snel gevonden worden.
Procescontrole van microbiologische analyses zorgt voor een degelijke borging van een kwaliteits- en/of HACCP-systeem.
Auteur: André Siccama, QA-manager en consultant bij Biosisto, kennispartner van VMT